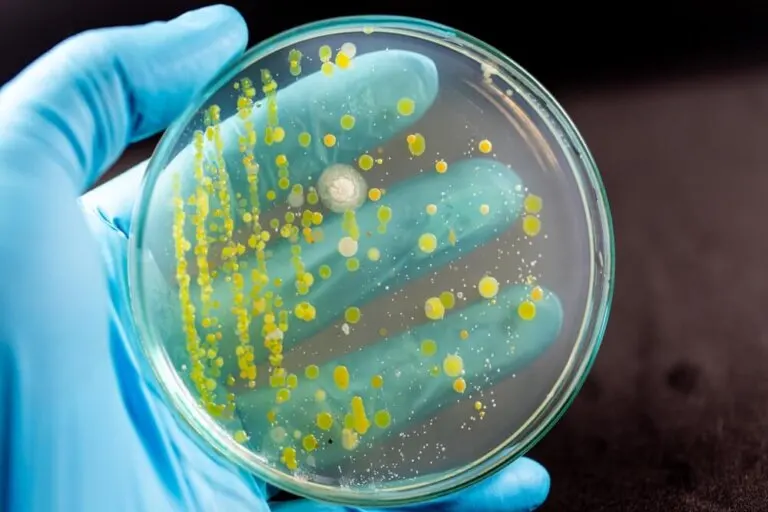

Tratamientos y prevención de la actinomicosis

Revisado y aprobado por la farmacéutica Sara Viruega
La actinomicosis es una infección bacteriana crónica que, comúnmente, afecta a la cara y el cuello. Por lo general, no causa enfermedad y no es contagiosa.
La actinomicosis usualmente es causada por una bacteria llamada Actinomyces israelii. Se trata de un organismo común que se encuentra normalmente en la nariz y en la garganta.
Cuando penetra en los tejidos faciales por un traumatismo, cirugía o infección, la bacteria causa un absceso y produce una protuberancia dura de color rojo intenso a rojo púrpura. Suele ocurrir a menudo con abscesos dentales o cirugía oral.
La actinomicosis afecta con más frecuencia a la cara y el cuello; sin embargo, la infección algunas veces también puede darse en el toráx, el abdomen, la pelvis u otras áreas del cuerpo.
Por otra parte, la infección también puede afectar a ciertas mujeres que han tenido un dispositivo intrauterino (DIU) para prevenir el embarazo.
Tipos de actinomicosis
La actinomicosis aparece con mayor frecuencia en hombres adultos y puede manifestarse de varias formas:
- Cervicofacial: se presenta con hinchazón mandibular. El origen más frecuente suele ser la caries dental.
- Torácica: la enfermedad pulmonar es secundaria a la aspiración de secreciones bucales.
- Abdominal: se puede deber a la rotura de la mucosa de un divertículo o del apéndice, o también a un traumatismo.
- Uterina: aparece en mujeres que tienen un DIU. Sus síntomas son flujo vaginal y dolor pelviano o hipogástrico.
- Generalizada: la infección se disemina por el torrente sanguíneo a numerosas áreas del cuerpo. Pueden aparecer diversos síntomas como dolor de espalda, cefalea o dolor abdominal.
Diagnóstico

El diagnóstico se confirma por la identificación de A. israelii mediante microscopía y cultivo del esputo, de pus o de una biopsia. El estudio por imágenes se hace a menudo en función de los resultados.
Las lesiones pueden simular proliferaciones malignas. Las lesiones pulmonares deben distinguirse de las de la tuberculosis y el cáncer. La mayoría de las lesiones abdominales son difíciles de diagnosticar, salvo por laparotomía.
La enfermedad progresa lentamente. El pronóstico está directamente relacionado con el diagnóstico temprano. Además, el pronóstico es más favorable en la forma cervicofacial.
No obstante, la actinomicosis empeora progresivamente en las formas torácica, abdominal y generalizada, en especial si afecta al sistema nervioso central.
Tratamiento de la actinomicosis

El tratamiento de la actinomicosis puede ser de tipo farmacológico y de tipo quirúrgico:
Tratamiento farmacológico
El tratamiento de la actinomicosis generalmente requiere antibióticos durante varios meses, incluso hasta un año.
Los antibióticos de primera elección son :
- Antibioticos betalactámicos del tipo penicilínicos, ya sea en forma parenteral u oral. No obstante, en pacientes alérgicos se puede utilizar:
- Macrólidos: la eritromicina y la azitromicina.
- Lincosaminas: la clindamicina o la lincomicina.
- Tetraciclinas.
El tiempo de duración del tratamiento con antibióticos debe ser prolongado de 2 a 6 semanas. Sin embargo, en los primeros días puede ser parenteral y posteriormente cambiar a vía oral, según la evolución. En algunos casos, puede haber tratamientos orales durante más de 12 meses.
La dosis de Penicilina G recomendada es de 20 millones de unidades en 24 horas. En casos de sospecha de infecciones, no es recomendado el uso de antibióticos hasta obtener muestra con fines de aislamiento del agente causal. La terapia intravenosa es recomendada para pacientes con una enfermedad más severa.
Tratamiento quirúrgico
Para las mujeres con actinomicosis ginecológica o pélvica, el tratamiento quirúrgico consiste en tratar síntomas obstructivos. Para ello se hace un drenaje en el sitio de su localización.
Además, el tratamiento de complicaciones obstructivas debe ser seguido de tratamiento de antibiótico durante un tiempo prolongado. Con esto se pretende evitar las complicaciones graves de la enfermedad.
En los casos de actinomicosis torácica, se realiza un drenaje y se tratan las complicaciones obstructivas, seguido de antibiótico. La extracción broncoscópica del cuerpo extraño es eficaz en todos los casos.
Todas las fuentes citadas fueron revisadas a profundidad por nuestro equipo, para asegurar su calidad, confiabilidad, vigencia y validez. La bibliografía de este artículo fue considerada confiable y de precisión académica o científica.
-
Herrero Martínez, J. A., Gómez Gómez, J., García Vázquez, E., & Hernández Torres, A. (2014). Actinomicosis. Medicine (Spain). https://doi.org/10.1016/S0304-5412(14)70794-2
-
Marenco, E. R., Rozier, E. G., & De Crescenzo, S. (1972). Actinomicosis abdominal. Prensa Medica Argentina.
-
Faba B., R., Wolff R., M., Lobos R., G., Peña G., P., & Trujillo V., S. (2014). Actinomicosis torácica por actinomyces odontolyticus. Rev. Chil. Enferm. Respir.
Este texto se ofrece únicamente con propósitos informativos y no reemplaza la consulta con un profesional. Ante dudas, consulta a tu especialista.







